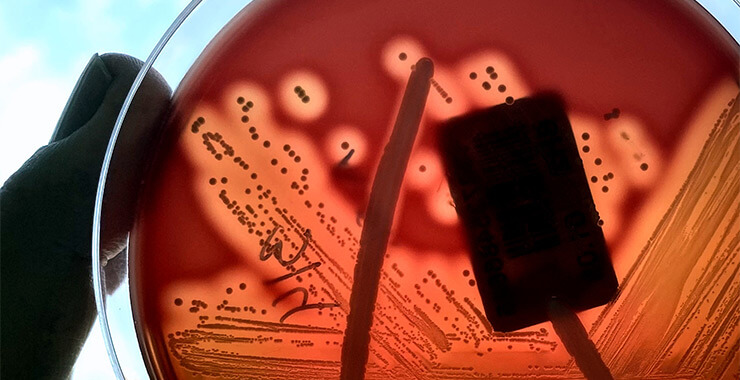
Strep bacteria in a petri dish

Sore throats are a common issue that most everyone must deal with from time to time. While a sore, dry, and red throat can be uncomfortable and disruptive to our lives, it’s more than that. It’s important to know the differences and causes of sore throats and strep throat and what treatment options are best.
Jump to the bottom of the article, if you are interested in strep throat in children what parents need to watch out for when it comes to their littles.
Why Some People Get Frequent Sore Throats
That scratchy, burning feeling in the back of your throat can be caused by six common reasons:
- Viral Infections: Most sore throats are caused by viral infections, such as the common cold or flu. These viruses are not strep throat. The infections are often accompanied by other symptoms like a runny nose, cough, and fever. Viral infections tend to get better on their own within one week.
- Bacterial Infections: Streptococcal bacteria (Group A Streptococcus) can cause strep throat, a more serious type of sore throat. Other bacteria can also contribute to throat infections, though this is less common.
- Allergies: Allergic reactions to pollen, dust, or pet dander can lead to throat irritation and soreness. Allergies often come with additional symptoms like sneezing, itchy eyes, and congestion.
- Environmental Factors: Dry air, especially during winter months, can dry out and irritate the throat. Smoking or exposure to secondhand smoke can also contribute to throat discomfort.
- Gastroesophageal Reflux Disease (GERD): Acid reflux can cause stomach acids to irritate the throat, leading to a sore throat, often accompanied by heartburn.
- Chronic Conditions: Conditions like chronic sinusitis or tonsillitis can cause recurrent sore throats due to ongoing inflammation or infection.
By the numbers: “Strep throat accounts for about 30% of sore throats in children, and 5% to 15% of sore throats in adults.” hopkinsmedicine.org
Primary Differences Between a Sore Throat and Strep
The term, sore throat, broadly refers to any discomfort or pain in the throat, usually caused by viral infections, allergies, or irritants. Symptoms can include scratchiness, soreness, and mild to moderate pain and treatment often involves home remedies and over-the-counter medications.
Strep throat is a bacterial infection caused by Group A Streptococcus bacterium. It is more serious than a common sore throat and requires specific medical treatment. Symptoms often include severe throat pain, fever, headache, and swollen lymph nodes. Strep throat can lead to complications if untreated, so it’s important to seek medical attention.

Treatment for Sore Throat
- Home Remedies: Gargling with warm salt water, drinking herbal teas, and staying hydrated can help soothe a sore throat. Honey and lemon can also provide relief.
- Over-the-counter Medications: Pain relievers such as ibuprofen or acetaminophen can help reduce pain and fever. Throat lozenges or sprays may also provide temporary relief.
- Avoid Irritants: Stay away from smoke and other irritants that can worsen throat discomfort.
- Rest and Hydration: Ensure plenty of rest and drink fluids to stay hydrated, which helps the body recover more quickly.
Treatment for Strep Throat
- Antibiotics: Strep throat requires treatment with antibiotics to clear the infection and prevent complications. It’s essential to complete the full course of antibiotics as prescribed, even if symptoms improve before the medication is finished. How it works: Antibiotic treatment of streptococcal pharyngitis virtually eliminates the presence of bacteria from the pharynx removing the risk of subsequent rheumatic fever.
- Symptomatic Relief: In addition to antibiotics, over-the-counter pain relievers and throat lozenges can help alleviate symptoms.
- Avoid Spreading the Infection: To prevent the spread of strep throat, practice good hygiene, such as frequent handwashing and avoiding close contact with others until you’ve been on antibiotics for at least 24 hours.
Interesting fact: Incidences of strep throat peaks during childhood and adolescents and accounts for 50% of all visits annually.

Strep Throat in Kids – What to Watch For
Strep throat can be particularly concerning in children. Watch for these key symptoms and signs:
- Severe Sore Throat: Children with strep throat often complain of a very sore throat that makes swallowing painful.
- High Fever: A sudden onset of high fever is a common symptom of strep throat in children. A high fever is defined as high if it is above 104°F or 40°C.
- Red and Swollen Tonsils: Look for red, swollen tonsils, sometimes with white patches or streaks of pus.
- Swollen Lymph Nodes: Tender and swollen lymph nodes in the neck are another indicator of strep throat.
- Rash: Some children may develop a rash known as scarlet fever, which can be a complication of strep throat.
- Behavioral Changes: Watch for irritability, decreased appetite, or unusual lethargy, which may indicate that a child is feeling unwell.
When to See a Medical Provider
If a sore throat persists for more than a week, is accompanied by high fever, rash, difficulty breathing or swallowing, or if you suspect strep throat, it’s important to consult a healthcare provider as soon as possible. Early diagnosis and treatment can help prevent complications and ensure a quicker recovery.
If you aren’t certain that it’s strep, an online video telehealth appointment is a great choice. One of our medical providers will help you determine if further testing and medications are needed.
Understanding the causes and differences between a sore throat and strep throat is essential for effective treatment and relief. While many sore throats can be managed with home remedies and over-the-counter treatments, strep throat requires antibiotic treatment to resolve and prevent complications. By being aware of the symptoms and when to seek medical care, can help you better manage throat discomfort and ensure a healthy recovery for yourself and your loved ones.
If you have any concerns about a persistent sore throat or suspect strep throat, don’t hesitate to reach out to Heavens Urgent Care or another healthcare provider for evaluation and guidance. We’re here when you need us!







